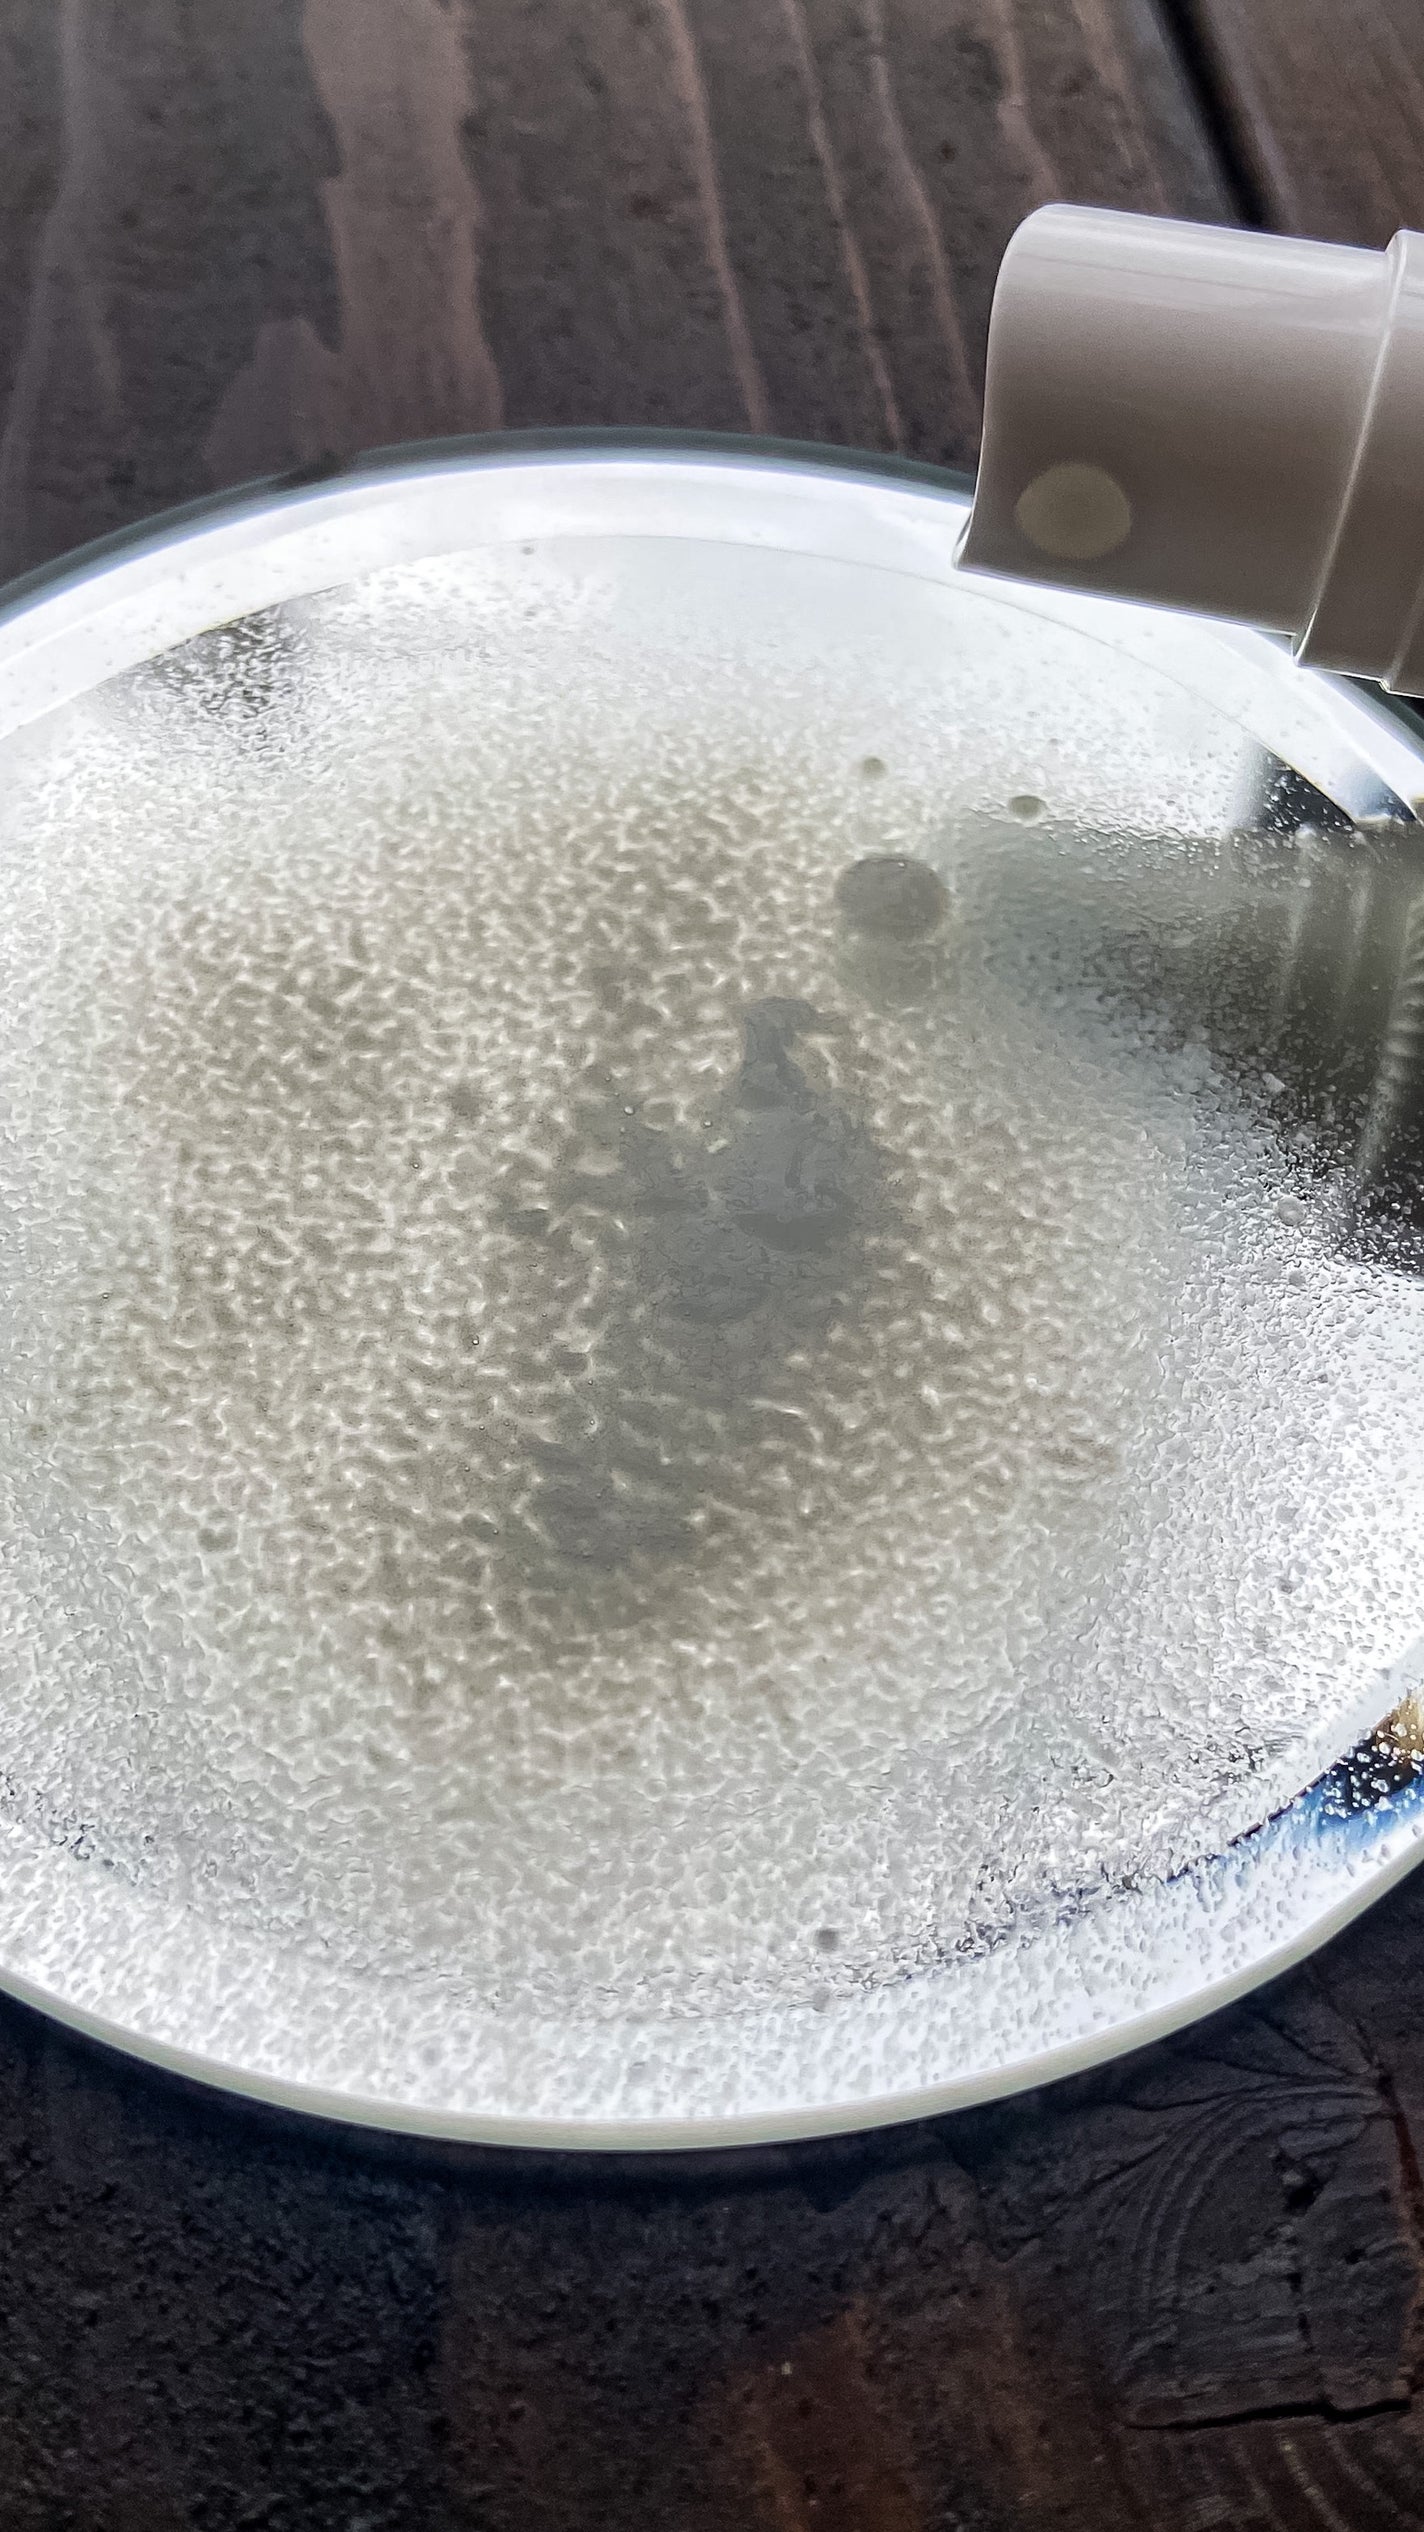
パフュームヘアパックインミスト Pink Breeze/Daleaf/アウトバストリートメントを使ったクチコミ(3枚目)

リピート何回したか分からん!!好きすぎて手放せない私のヘアケアアイテム️🩵こんにちは、k-nightです٩(ᐛ)وDaleafのコレ、使ったことある?マジでオススメ✨✎︎Daleafパフュームヘアパックインミストお風呂上がりドライヤーの前に髪...
もっと見るおすすめアイテムDaleaf×アウトバストリートメント
| 商品画像 | 商品情報 | 参考価格 | 評価 | ランキングIN | 特徴 | 商品リンク |
|---|---|---|---|---|---|---|
Daleaf パフュームヘアパックインミスト Pink Breeze |
| スペシャルヘアケアランキング第34位 | クリームタイプ・ミストタイプにもなる2way♡ 濡れた髪・乾いた髪どちらにも使えて 香水のような良い香り𓂂𓏲𓆸܀ | 詳細を見る | ||
Daleaf LPTケラチンリペア ノーウォッシュトリートメント |
| スペシャルヘアケアランキング第117位 | パサついた髪に ツヤを与え、ベタつきが気にならない サラツヤの触り心地☺️❤️繊細なラメが入っていて マジ可愛い | 詳細を見る | ||
Daleaf パフュームヘアパックインミスト Ophero Musk |
| スペシャルヘアケアランキング第59位 | ミストとトリートメントを割ったような とろみのあるテクスチャーで、 髪にしっとりとした潤いと、 ムスクの香りが広がります♥ | 詳細を見る |
アウトバストリートメントランキング
| 商品画像 | 商品情報 | 参考価格 | 評価 | ランキングIN | 特徴 | 商品リンク |
|---|---|---|---|---|---|---|
melt メルト モイストコンディショニングウォーター | 1,430円 |
| ヘアケア・スタイリングランキング第20位 | みずみずしいテクスチャーで 髪に揉み込んだ手はサラッと🖐🏻◎まさに髪の化粧水 軽くてまとまる髪に♡ | 詳細を見る | |
melt スムース コンディショニング ウォーター | 1,430円 |
| ヘアケア・スタイリングランキング第17位 | 軽いとろみはありますが 重さはなく べたつかず サラっとなじませやすい ウォーターテクスチャー | 詳細を見る | |
plus eau リポアオイル | 1,540円 |
| ヘアケア・スタイリングランキング第37位 | 透明でとろっとしたテクスチャーで髪に伸ばしやすくしっとりツヤ感 でもドライヤーのあとはさらっとしています。 | 詳細を見る | |
エッセンシャル エッセンシャル プレミアム ウォータートリートメント EXスムース | 1,414円〜 |
| ヘアケア・スタイリングランキング第43位 | 乾かすとつるんとした手触りの髪になるのも良き◎ウォーターなので、使用感が軽いところも良いな〜〜と思いました | 詳細を見る | |
オルビス トリートメントヘアウォーター | 1,100円〜 |
| ヘアケア・スタイリングランキング第46位 | タオルドライした後に全体に吹きかけてから乾かすだけで、サラサラヘアになります。 | 詳細を見る | |
エッセンシャル エッセンシャル プレミアム ウォータートリートメント ナチュラルモイスト | 1,414円〜 |
| ヘアケア・スタイリングランキング第60位 | ドライ後は フワッと風になびく様な 軽くて程よくまとまり感のある仕上がり | 詳細を見る | |
miseenscene パーフェクトセラム オリジナルセラム | 1,540円 |
| ヘアケア・スタイリングランキング第32位 | とろみが濃いめのオイルだけどかわかすとサラサラ〜ってなるよ。 | 詳細を見る | |
plus eau ハイドロミストN | 1,540円〜 |
| ヘアケア・スタイリングランキング第98位 | スプレータイプだから 簡単にささっと振りかけることができて 普段のケアに簡単に取り入れられます! | 詳細を見る | |
MEMEME MEMEME クラッシュジェルトリートメント | 1,540円 |
| ヘアケア・スタイリングランキング第146位 | ベタつかず、さらさらと自然にまとまる感じ! | 詳細を見る | |
MQURE モレキュラーリペアヘアセラム | 3,190円 |
| ヘアケア・スタイリングランキング第168位 | たった4分なのに美容院でトリートメントした後みたいに しっとりした仕上がりで指通りもなめらかに✨ | 詳細を見る |
ちゃーまんさんの人気クチコミ
話題で完売続出の香水。大好きなザラとジョーマローンのコラボフレグランス🎠ZaraEmotionsCollectionbyJoLOVES🎠男女問わず使用できる香りのオードパルファン8種の香りの中から3種を購入してみました。40ml¥2,990⌖...
もっと見る
176
14
- 2020.06.15
ムシムシする季節の到来ですね🌂友達や彼にも相談しづらいデリケートゾーンのムレ、ニオイ、黒ずみ…🌀お風呂の時にボディソープでゴシゴシ洗って終わり!なんて方は美意識の高いLIPSユーザーさんにはいませんよね?!デリケートゾーンのケアは欧米では常識...
もっと見る
173
36
- 2020.06.13
女優肌へ導くSNSなどやクチコミサイトでも話題のクッションファンデ。🎠エクスボーテホワイトカバークッション🎠●レフィル(スポンジ付)全2色17g(1日1回の使用で約2ヶ月分)税抜¥3,900●コンパクトケース(鏡付)税抜¥9007つの機能を1...
もっと見る
150
3
- 2020.06.04
色ムラや毛穴の凹凸など、肌悩みを改善する進化したカラー下地🌈下地にはもちろんですが、ファンデーションの上からでも肌補正が出来る万能下地🌐悩みに応じてカラーは4色展開🌈ピンクを使用していますが、血色感が出で顔色が明るく感じます💕こちらを使用して...
もっと見る
149
11
- 2019.10.10
ヨーグルト好きの女性に朗報🥛✨肌の保湿力を高め水分量を増やす美肌のためのヨーグルト🎶♡・・・・・・♡・・・・・・♡・・・・・・♡・・・・・・♡森永アロエヨーグルト🌿アロエの力🌿100g148円(税抜)エネルギー🌐機能性表示食品🌐♡・・・・・・...
もっと見る
148
64
- 2019.10.09
LIPSのプレゼント企画に当選し、エッセンシャルflatさんからいただきました🌈ありがとうございます😊くせ、うねりの為のエッセンシャルflatの新タイプのシャンプー&トリートメント。———❏❏❏❏❏——————❏❏❏❏❏———🍒からまり抑制成...
もっと見る
146
1
- 2020.04.16
商品詳細情報Daleaf パフュームヘアパックインミスト Pink Breeze
- ブランド名
- Daleaf(ダリーフ)
- ランキングIN
- 全体ランキング年代別ランキングスペシャルヘアケア 10代 第35位スペシャルヘアケア 20代 第35位スペシャルヘアケア 30代 第35位スペシャルヘアケア 40代以上 第35位洗い流さないトリートメント 10代 第35位洗い流さないトリートメント 20代 第35位洗い流さないトリートメント 30代 第35位洗い流さないトリートメント 40代以上 第35位肌質別ランキングスペシャルヘアケア 普通肌 第35位スペシャルヘアケア 脂性肌 第35位スペシャルヘアケア 乾燥肌 第35位スペシャルヘアケア 混合肌 第35位スペシャルヘアケア 敏感肌 第35位洗い流さないトリートメント 普通肌 第35位洗い流さないトリートメント 脂性肌 第35位洗い流さないトリートメント 乾燥肌 第35位洗い流さないトリートメント 混合肌 第35位洗い流さないトリートメント 敏感肌 第35位髪質別ランキング
- 容量・参考価格
- バリエーション
- 150ml
- カテゴリ
- ヘアケア・スタイリング > スペシャルヘアケア > アウトバストリートメント
![LIPS[リップス] - コスメのクチコミ検索アプリ](https://cdn.lipscosme.com/assets/lips_logo_full_2022-bc7b4bc9dd66035bc5696b0d16bc3d38a7be357186656c039e68cc4cf21ae675.png)

コメント